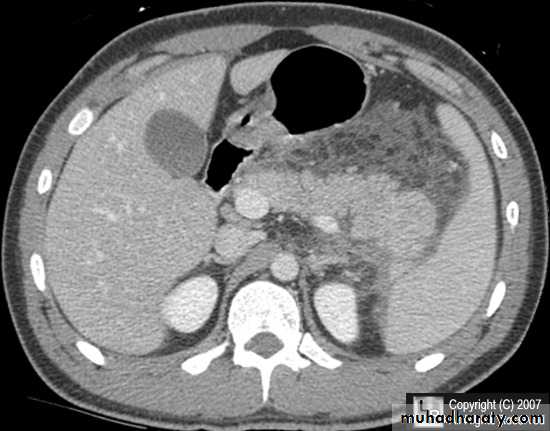

Fifth stage
RadiologyCT scan2
د. هديل
10/4/2017
CT of the brain tumors & abdomenBrain tumors :
Meningioma
Benign tumor arise from the arachnid cells of the meningeal covering of the brain are most common primary intracranial neoplasm
Usually present in middle age female
it is well defined extra axial , located mainly at the convexity of the skull periphery
rounded or sessile , plaque like , specially the tumor arise from the cribriform plate , or those arise from the petrus bone , planum spheniodale , or from skeleton of the pituitary fosse .
CT finding
meningioma presented as isodense area or slightly hyper density area with surrounded crescent of hypo density ( csf cap ) post contrast injection the lesion enhance homogeneously with enhancing Dural tail .
20 % show calcification
hyperostosis & thickening of the near by bony part of the skull & diplioc space .
it may be associated with little or no peri focal edema .
if the lesion associated with central necrosis with large perifocal edema meningio sarcoma should be excluded .
Glioma
Comments primary interracial tumor , vary greatly in malignancy , have many names depending on the histological type :astrocytoma
oligodendroglioma both of them are well differentiated slowly growing t.
gliobtastoma multiforme G IV highly malignant t. named also as butterfly G. arise from the anterior or posterior aspect of the corpus callosum , extend & spread to both cerebral hemispheric sides
grading of malignancy of G. depending on the following :
well defined or irregularity of the lesion
surrounding edema present or absent
associated shifting of midline & crossed midline lesion
contrast enhancement
associated hemorrhage , necrosis , & cystic formation
seeding via csf & dissemination .
Low grade G. I well or ill defined lesion iso dence to the brain tissues , not associated with oedeme , no Enhancement , no associated Hemorrhage , necrosis .
From G II , III, various previous finding
IV( glioblastoma multiforme ) are highly malignant have all previous mentioned features .
Posterior fosse tumor
Medullo blastomaAge incidence between 5-15 Y represent about 35-40 %of PFT
Arise from the midline mainly within or from the roof of the 4 TH ventricle fill the fourth ventricle & seeding via the csf so can seen in the distal part of the spinal canal .
CT finding as well circumscribed lesion heterogeneous in density ,have solid & cystic part , with also scattered calcification little surrounded edema , the solid part is enhance
90 % present with obstructive hydrocephalous at the level of the 4Th V. with dilatation of the lateral V. ( body , frontal , temporal & third ventricle )
40 % of child have secondary metastasis at the time of presentation
Haemangioblastoma
Arise from per vascular pericyte
GII to III in their malignancy
Age between 30 -65 Y , represent 10 % of PFT
Intra axial t. arise from the cerebellum , brain stem ,spinal cord
CT finding , as smooth walled cystic lesion with enhancing mural nodule rarely calcified .
Pilocytic astrocytome
Present in the childhood 5-15 YArise within the vermis & cerebral hemisphere
CT finding appear as well circumscribed lesion hypo or hyper dense & growing mainly with expansion , usually large lesion solid or cystic or both of them , with , enhancing mural nodule 20 % show calcification of the nodule , may be associated with edema .
Secondary metastasis
Old age group above 50 Y , any lesion within the cerebellar hemisphere it is secondary metastasis unless proven otherwise F. from breast CA M. from bronchogenic CA .
Appear as nodular single or multiple lesion hypo dense or hyper dense .
Surrounded by per focal edema
Enhanced as solid or ring pattern of enhancement .
Supra seller T.
Cranio phyrengiomaTumor situated above the sella tursica arise from the remnant of the rathekes pouch , an embryonic structure from which the pituitary gland is partly formed .
CT finding
The t. might invade sella tursica , then go anterior , posterior or upward , sometime reach the third ventricle .
Deformity of the supra sellar cistern
The t. have solid & cystic component , post contrast solid part will get enhancement , flecks of calcification seen around the lesion as multiple rings .
The lesion might obstruct the third ventricle &present with obstructive hydrocephalous .
Hydrocephalous
2 typesObstructive ( non – communicating )
Craniophyrengioma
Medulloblastoma
Ependymoma
Aquiduct stenosis , comments cause of obstruction being congenital in nature .
Non –obstructive ( communicating )
No obstruction of the ventricular pathway , but the absorption of the csf at the level of arachnoids' granulation is occluded secondary to lodge by blood clot or inflammatory cell or infection post meningitis most commonly to occur post SAH .
Hydatid cyst
CT abdomen
Hydatid cystAppear as large oval hypo dense area density of fluid with well defined margin , sometime at their periphery multiple flecks of calcification are seen at their periphery .
Hydatid cyst with daughter cyst , appear as multiple hypo densities rounded area within the main loculi with multiple rim of
calcification
Secondary metastasis in the liver
Multiple rounded hypo density areas of different density , shape & different size .
Pattern of enhancement is either uniform , target or bulls eye pattern .
Hepato megaly .
Hydatid cyst within the liver
Secondary metastasis within the liver
Pancreatitis
Patient present with abdominal pain , vomiting with or without jaundice , increase amylase levelCT finding
Enlargement of the pancreas focal or generalized increase in size .
Hypo density within the pancreas focal or generalized due to the edema .
Peri pancreatic fluid collection & edema around the pancreas .
The fluid around the pancreas if persist more than 6 w become encysted leading to the pancreatic pseudo cyst any area could be affected .
Edema of the wall of the stomach .